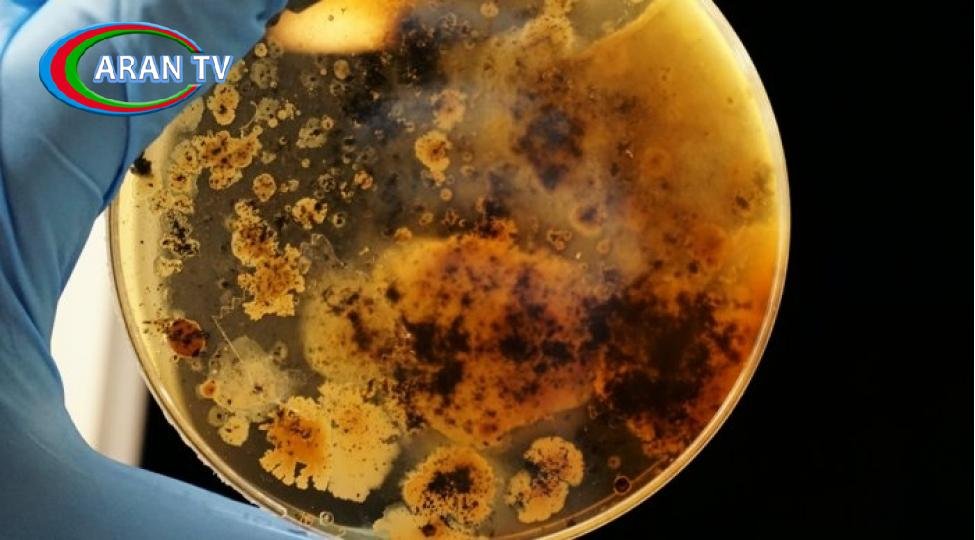

Mikrob, bakteriya və ya virus
“Kiçik qatillərin” hansı daha təhlükəlidir?
Mikrob, bakteriya və viruslar bizi əhatə edən, hətta daxilimizə nüfuz edə bilən varlıqlardır. Sayı milyonlarla, milyardlarla olan bakteriya, virus və mikrobların bəziləri insan orqanizmi üçün faydalıdır, bəziləri isə xəstəliklər törədirlər.
Bəs onlar arasındakı fərq nədir? Viruslar bakteriyalardan nə ilə fərqlənirlər? Onlardan hansı daha təhlükəlidir?
Mikroorqanizmlər dünyası
Mikroblar gözlə görülə bilməyəcək qədər kiçik olan canlıların toplu adıdır.
Arxeya, göbələklər, protistlər, viruslar və bakteriyalar bu krallıqda yaşayır. Bunlar planetdə təkamül prosesində ortaya çıxan ilk canlılardır. Dünyanın əsl sahibləridir, demək olar ki, hər mühitdə yaşayırlar və inanılmaz bir həyat qabiliyyətinə malikdirlər.
Yalnız bakteriya kütləsinin bütün bəşəriyyətin kütləsindən 1166 dəfə çox olduğu təxmin edilir. Onların sayı 5 nonilyona çatır (30 sıfırı olan rəqəmlər). Bir qram torpaqda orta hesabla 40 milyon belə canlı yaşayır. Virusları isə ümumiyyətlə, saymaq mümkün deyil. Bir kvadratmetr ölçüdə bir sahədə milyonlarla bakteriyalar və milyardlarla viruslar ola bilər. Dünyanın görünməz sakinləri məişət əşyaları arasında ən çox xalçalar, qabyuyan süngərlər, kompüter klaviaturaları, əlüzyuyan, masa və cib telefonlarının üzərində toplanırlar.
Bakteriyaları digər mikroblardan fərqləndirən nədir?
Dünyadakı orqanizmlərin əksəriyyəti hüceyrələrdən ibarətdir. Hüceyrələr bütöv bir parçanı yaradan “saplardır”. Hər bir hüceyrənin nüvəsi var. Bu, genetik materialın saxlanması üçün lazımdır, hüceyrələrin böyüməsinə və çoxalmasına nəzarət edir.
Bakteriyaların adətən cəmi bir hüceyrəsi olur. Bu varlıqların fərqli bir çoxalma və DNT ötürmə üsulu var. Onlar prokariotlar da adlandırılırlar.
Bakteriyalara oxşar digər qrup arxeyalardır. 1990-cı illərədək onlar ayrıca qrupa ayrılmamışdı.
Bakteriyaların əksəriyyətinin zərərsiz olduğuna inanılır. Bəziləri hətta faydalıdır – infeksiyaların qarşısını alır, bağırsaqlarda qidanın sorulmasına kömək edir və s.
Ancaq bəzi bakteriyalar kiçik qatillərdir. Taun, vəba, qarayara və s. kimi xəstəliklərə səbəb olurlar. Təxminən 39 trilyon bakteriya insan bədənində sığınacaq tapmışdır. Onların ümumi çəkisi iki kiloqrama çatır.
Bəs virus nədir?
Virusun ümumiyyətlə hüceyrə quruluşu yoxdur. Bu onun əsas fərqləndirici xüsusiyyətidir. Viruslar başqalarının hüceyrələrini ələ keçirən və orada öz növlərini çoxaltmağa məcbur edən məşhur “soyğunçulardır”.
Virus bakteriyadan min dəfə kiçikdir. Buna görə digər mikroblara belə hücum edə bilər.
Düzdür, viruslar arasında da yaxşıları var – bakteriyofajlar. Bəzi hallarda, onlar bakterial infeksiyaların müalicəsi üçün antibiotik əvəzinə istifadə olunur. Bakteriyofajlar bədəndə patologiyaya səbəb olan mikrobu taparaq öldürür.
Hansı daha təhlükəlidir, virus, yoxsa bakteriya?
Viruslar daha təhlükəli hesab olunur. Bakteriyalardan fərqli olaraq onlar genetik mutasiyaya uğraya bilirlər.
İldən-ilə viruslar daha qəddar olur, dərmanlara qarşı müqavimət qazanır və hücum etdikləri orqanizmlərin siyahısını genişləndirirlər. Məsələn, əvvəllər yalnız heyvanlara xas olan xəstəliklər artıq insanlara keçməyə başlayıb. Bundan əlavə, virusların hüceyrələrdən tamamilə çıxarılması son dərəcə çətindir. Parazitlər bədənimizdə kök sala və həyatımız boyunca xroniki xəstəliklərə səbəb ola bilərlər.
Nubar Süleymanova, “İki sahil”